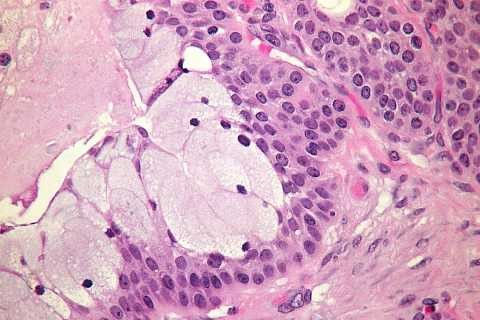

Animals of Undetermined Significance
A humorous take on five pathology residents in their professional and personal lives.

Meet the Pathology Residents
Marla is a new mother looking for a place to “pump,”
Sana is a first-year resident looking for a place to “pray.”
Neil is a good-looking Instagrammer with lots of admirers, while Pixie is an ambitious resident with almost no admirers.
Lastly, the elusive and secretive Jiang, their Chief Resident.
Together, they encounter strange, annoying, occasionally abusive attendings, as well as obnoxious and ridiculous clinical staff and situations. They each face struggles in their personal lives, in family, friendship, and love.
A humorous take on five pathology residents in their professional and personal lives.
Amy's Bookshelf Reviews
“It’s a fun read, and many parts are humorous. It's an interesting look in a residency program, especially in pathology, which is the study of the cause and effects of diseases and injury. An embraceable story. An emotional rollercoaster. Animals of Undetermined Significance on audiobook is a definite listening recommendation by Amy's Bookshelf Reviews.”
Up A Notch
I chose to read Animals of Undetermined Significance as I felt i would be able to relate to the pathology aspects of the story --- but what kept me hooked was the characters, each having their own individual personality and character arc. The internal struggle between giving up and going on is something we all experience and the stories have been crafted to deliver life lessons with a touch of humor, enough to lighten up the mood without dampening the spirit. This book was a soft, breezy read and I look forward to reading more of the author's books in the future.”
Dr. Hagar, Pathology Resident
They say don’t judge a book by it’s cover, but that was what first drew me to this book! And then as I started reading I found myself transported somewhere else like I was gazing into my future as a pathology resident. I was laughing, crying and everything in between. Although this book is fictional, it really hits home. I also love that there’s an index of terms so that non medical people can equally enjoy! Definitely would recommend!
Dr. Danielle Ward/Aspiring Minority Doctor
…it was fun reading the interactions between the pathology residents and those from different specialties. I also enjoyed following along with each character and I was able to find small bits of humor throughout the book. I recommend for anyone who wants an enjoyable and relaxing read.
Dr. Rebecca Radcliffe Board Certified Pathologist, HCA Florida
“This was a very fun read! The book is filled with characters who I swear I know from my own pathology residency. Each character was well-written and you could really feel their personalities jump off the pages.”

The original copy tells the stories of 5 residents as they face challenges in their personal and professional lives. It is a serious- but funny- novel that tackles issues such as sexism, racism, bullying in the workplace, motherhood and working moms.
​
The image on the front cover, "Dumbo," was a finalist in the 2020 calender of the American Society of Cytopathology. It is formed of benign GI cells.

Narrated by the talented Jane Boyer, the stories come to life hilariously and entertainingly.
​
​
Jane Boyer is a voice artist with experience in a wide range of genres, from engaging e-learning modules and immersive audiobooks to persuasive commercials, polished corporate narrations, and compelling film voiceovers. She has a degree in theater and speech.

The 2nd Edition has pathology related images at the beginning of each chapter, an expanded index of medical terms, and a QA with the author.